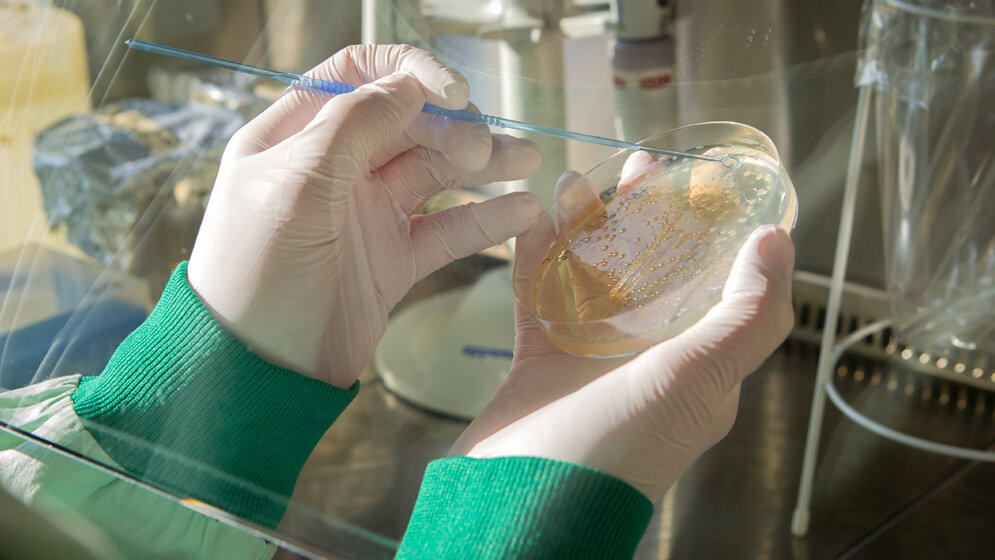
InfectoGnostics_Forscherin_traegt_Probenmaterial_auf_eine_Agarplatte_auf_InfectoGnostics_Fotostudio_Ebenbild.jpg Probenmaterial auf Agarplatte

Patienten bringen hochresistente ESBL-Keime mit
Infektionen mit den eigenen ESBL-Erregern blieben zwar in der Studie noch ein Ausnahmefall, allerdings zeigten die Forscher, dass die Erreger ihre Resistenzgene an andere Bakterienstämme in der Klinik weitergeben könnten. An der klinischen Studie beteiligt waren InfectoGnostics-Wissenschaftler des Uniklinikums Jena, des Industriepartners Abbott sowie des Leibniz-Instituts für Photonische Technologien. Die „Extended-Spectrum-Betalaktamasen“ (ESBL) sind Enzyme, die für Bakterien wie eine Lebensversicherung wirken: Ist das Bakterium einmal in der Lage, ein solches Enzym zu bilden, kann es sich erfolgreich gegen zahlreiche Antibiotika zur Wehr setzen, die in Kliniken und auch beim Hausarzt zum Einsatz kommen. Die Folge: Ärzte müssen schon seit einigen Jahren immer häufiger zu Reserve-Antibiotika greifen, um Infekte überhaupt in den Griff zu bekommen. Dieser Kreislauf führt dazu, dass mittlerweile viele Antibiotika bereits wirkungslos sind.
Kolonisierung des gesunden Darms
ESBL-bildende Bakterien breiten sich nicht hauptsächlich in Krankenhäusern aus, sondern kolonisieren vor allem über die Nahrungsaufnahme den gesunden Darm. Die Kolonisierung selbst ist nicht gefährlich, solange die Betroffenen gesund sind. Bei schweren Operationen oder bei Immunschwäche können die Keime jedoch zu Infektionen führen. Ein Team des InfectoGnostics Forschungscampus Jena hat nun in einer Beobachtungsstudie die Kolonisierungsrate bei Patienten untersucht, die neu ins Krankenhaus eingewiesen werden und ausgewertet, ob sie durch den Klinik¬aufenthalt steigt. Darüber hinaus analysierten die Forscher, welche Faktoren die Kolonisierung mit dem Erreger bedingen.
Fast jeder vierte Patient aus einem Pflegeheim betroffen
Für die Studie wurden 1.334 Patienten auf ESBL-bildende Darmkeime getestet: zunächst bei der Aufnahme in der Klinik, dann nach Abschluss der Behandlung und – falls möglich – auch nochmal sechs Monate nach dem Klinikaufenthalt. Die enge Zusammenarbeit zwischen Klinik, Forschung und Industrie erwies sich dabei als großer Vorteil, wie die Hauptautoren der Studie, Dr. Stefan Hagel, Dr. Oliwia Makarewicz und Prof. Mathias Pletz vom Institut für Infektionsmedizin und Krankenhaushygiene des Uniklinikums Jena, berichten: „An der Klinik konnten wir die relevanten Proben sammeln und zeitgleich wichtige Patientendaten erheben, während die Abbott- und IPHT-Kollegen Daniel Weiß und Prof. Dr. Ralf Ehricht den am Campus entwickelten Test CarbDetect AS-2 für die Analyse der Rektalabstriche angepasst haben“, erklärt Dr. Makarewicz. In ihrem mikrobiologischen Forschungs¬labor wurden die Testergebnisse gemeinsam von den Partnern analysiert.
Bei jedem achten getesteten Patienten nachweisbar
Die Ergebnisse der Studie zeigten, wie weit verbreitet ESBL-bildende Bakterien bereits heute in der Bevölkerung sind: Bei jedem achten getesteten Patienten (12,7 Prozent) konnte bei der Aufnahme in die Klinik ein ESBL-Keim nachgewiesen werden. Noch dramatischer ist die Situation jedoch bei Patienten aus Alten¬pflege¬heimen: Fast jeder vierte Patient (23,8 Prozent) trägt hier bereits die multiresistenten Keime in sich. Trotz dieser hohen Kolonisierungsrate mit ESBL-Erregern traten tatsächliche Infektionen mit dem ‚eigenen‘ ESBL-Keim während des Krankenhausaufenthalts äußerst selten auf: In der Studie infizierte sich lediglich ein einziger Patient mit dem eigenen Erreger.
Gefahr durch Transfer von Resistenzgenen
Die geringe Zahl an Infektionen in der Klinik sei allerdings noch kein Grund zur Entwarnung, wie Dr. Makarewicz erläutert: „Einerseits ist die Anzahl der tatsächlichen Infektionen in Abteilungen wie der Onkologie, Geriatrie oder der Intensivstation ungleich höher, da dort hauptsächlich Risikopatienten mit geschwächtem Immunsystem behandelt werden. Andererseits konnten wir in unseren Analysen erneut zeigen, dass die Erbinformationen für Multiresistenzen über Plasmide auch auf andere Bakterienarten im Darm übertragen werden – neue multiresistente Erreger können somit sehr schnell entstehen. Man muss davon ausgehen, dass solche Kolonisierungskeime die Resistenzen an Krankenhauskeime weitergeben können. Die Rolle dieser kleinen DNA-Stränge bei der Weitergabe von Resistenzen wird im klinischen Alltag bislang noch viel zu wenig beachtet.“ (idw, red)
Hagel S, Makarewicz O, Hartung A, Weiß D, Stein C, Brandt C, Schumacher U, Ehricht R, Patchev V, Pletz MW: ESBL colonization and acquisition in a hospital population: The molecular epidemiology and transmission of resistance genes. PLOS ONE (2019), DOI-Link: http://dx.doi.org/10.1371/journal.pone.0208505.
Artikel teilen